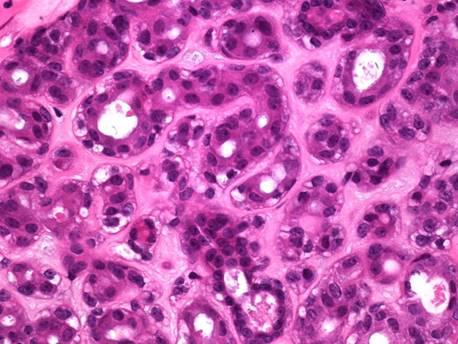

Reporte de Caso
Adenomioepitelioma benigno de mama. Reporte de caso y revisión de la literatura
Benign breast adenomyoepithelioma. Case report and literature review
Adenomioepitelioma benigno de mama. Reporte de caso e revisão da literatura
Adenomioepitelioma benigno de mama. Reporte de caso y revisión de la literatura
Medicina U.P.B., vol. 39, núm. 1, pp. 75-80, 2020
Universidad Pontificia Bolivariana

Recepción: 20 Mayo 2019
Aprobación: 25 Octubre 2019
Resumen: Los adenomioepiteliomas de mama son tumores inusuales caracterizados por la proliferación bifásica de células epiteliales y mioepiteliales. Aunque la mayoría son benignos, tienen riesgo de recurrencia local y los casos con transformación maligna pueden tener riesgos de metástasis. El diagnóstico clínico e imagenológico no tiene rasgos característicos y en general se requiere de la resección completa de la lesión, para estudio microscópico y apoyo en la inmunohistoquímica. Al haber riesgo de recidiva local se recomienda resección con márgenes amplios. Para esta revisión se utilizó como fuente primaria de información la historia clínica y se realizó una búsqueda de la literatura relacionada con el uso de las palabras breast y adenomyoepithelioma, en la base de datos Pubmed, durante los últimos 10 años, en inglés y español, para discutir los aspectos relacionados con el tema.
Palabras clave: neoplasias de la mama, adenomioepitelioma, inmunohistoquímica, ultrasonografía, mastectomía.
Abstract: The breast adenomyloepithelioma is an unusual tumor characterized by the biphasic proliferation of epithelial and myoepithelial cells. Although most of these tumors are benign, they may be at risk of local recurrence and few cases with malignant transformation may have chances of metastasis. The clinical and imaging diagnosis has no characteristic features and, in general, a complete resection of the lesion is required for microscopic study and support in immunohistochemistry. When risk of local recurrence is present, a resection with wide margins is recommended. The clinical history was the primary source of information on the case and, as a complement, there was a literature search, in both English and Spanish, focused on the use of the words "Breast" and "Adenomyoepithelioma" and was retrieved from Pubmed database publications from the last 10 years.
Keywords: breast neoplasms, adenomyloepithelioma, immunohistochemistry, ultrasonography, mastectomy.
Resumo: Os adenomioepiteliomas de mama são tumores incomum caracterizados pela proliferação bifásica de células epiteliais e mioepiteliais. Ainda que a maioria são benignos, tem risco de recorrência local e os casos com transformação maligna podem ter riscos de metástase. O diagnóstico clínico e de imagem não tem traços característicos e em geral se requere da ressecção completa da lesão, para estudo microscópico e apoio na imuno-histoquímica. Ao haver risco de recidiva local se recomenda ressecção com margens amplas. Para esta revisão se utilizou como fonte primária de informação a história clínica e se realizou una busca da literatura relacionada com o uso das palavras breast e adenomyoepithelioma, na base de dados Pubmed, durante os últimos 10 anos, em inglês e espanhol, para discutir os aspectos relacionados com o assunto.
Palavras-chave: neoplasias da mama, adenomioepitelioma, imuno-histoquímica, ultrassonografia, mastectomia.
INTRODUCCIÓN
Las lesiones proliferativas de la glándula mamaria surgen principalmente en la unidad ducto lobulillar terminal (TDLU), la mayoría son epiteliales1. Las células mioepiteliales basales derivadas del ectodermo se localizan entre las células epiteliales luminales y la membrana basal, se conoce como la capa basal y expresan citoqueratinas (CK) CK5, CK14 y CK17, actina del músculo liso (SMA), miosina de cadena pesada (MCP) y p632. Las células mioepideliales se asocian con el tejido muscular y tiene capacidad contráctil, soportan el parénquima y contribuyen a la producción de laminina y colágeno3. Los tumores con proliferación bicelular, tanto de origen epitelial como de células mioepiteliales se llaman adenomioepiteliomas (AME), se han reportado en la piel, glándulas salivales, pulmones y mama, aunque esta última localización es poco frecuente4.
El AME de mama es un tumor raro, de causa desconocida, que se asemeja al adenomioepitelioma de glándulas salivales, como reportó por primera vez Hamperl5, que lo describe como un tumor con patrón heterogéneo debido a la proliferación variable de células epiteliales y mioepiteliales. La incidencia del AME del seno no se ha determinado debido a su rareza, y escasez en literatura, con pocos informes de casos6. En lengua inglesa se habían reportado 125 pacientes hasta el año 2001 en una serie de casos7. A excepción de esta serie de casos, solo se han hecho cuatro estudios de series exhaustivas1,8,9,10.
Casi todos los reportes han sido en mujeres, aunque hay casos raros en hombres10, de 60 años en promedio (rango 26 a 82 años)1. Se manifiesta como una masa mamaria solitaria, palpable de 20 a 50 mm11,12. No se reportan factores de riesgo para este tipo de tumor13,14. Los signos mamográficos y ecográficos son inespecíficos13. Todos los casos han sido esporádicos y no familiares.
Histológicamente consiste en células mioepiteliales mezcladas con elementos luminales en diferente proporción, los rasgos distintivos son el contraste entre la tinción oscura del citoplasma de las células epiteliales cúbicas que recubren los conductos mamarios, y el citoplasma claro o pálido de las células mioepiteliales circundantes (Figura 1)15.
La Organización Mundial de la Salud (OMS) clasificó los AME en 2012 en benignos y malignos16. La mayoría de AME son benignos y en general el pronóstico es bueno14,17,18. Las características morfológicas que predicen el potencial de recidiva local y metástasis no están bien establecidas19.
Tavassoli clasificó las lesiones mioepiteliales de la mama en: mioepiteliosis, AME y mioepitelioma maligno. Subclasificó los AME según el patrón histológico en: células fusiformes, lobuladas y tubulares1. El patrón más común es el tipo tubular, caracterizado por proliferación equilibrada entre túbulos y células mioepiteliales. Se sugiere que los diferentes tipos histológicos predicen el comportamiento clínico, donde la mayoría son benignos7,20. La generalidad de AME tienen configuración papilar y han sido considerados una variante del papiloma intraductal8,21,22.
Las células ductales y mioepiteliales se tiñen a través de inmunohistoquímica con anticuerpos específicos, el primero reacciona a las citoqueratinas (CK) AE1/3, CAM 5.2 y CK 721,9, mientras que el segundo es resaltado por p63, actina de músculo liso (SMA), cadenas pesadas, CK5, CD10, calponina, actina, y S10021,9. Para el estrógeno es negativo o débilmente positivo en un patrón en parches. Los receptores de progesterona y Her2/neu son negativos8,23. La Tabla 1 muestra las características inmunohistoquímicas del tumor.
Tabla 1. Características inmunohistoquímicas del adenomioepitelioma.

El objetivo de este estudio es reportar el primer caso en Colombia de una paciente con AME de la mama y hacer una revisión de la literatura con respecto al diagnóstico y tratamiento de esta entidad.
CASO CLÍNICO
Paciente de 78 años, mestiza. Con estudio universitario en licenciatura y soltera. La paciente tiene como antecedente patológico osteoporosis, niega cirugías previas, tampoco fuma ni consume alcohol u otras drogas.
Consultó en octubre 2018 a la Clínica Medellín, institución privada de tercer nivel de atención de la ciudad de Medellín (Colombia), por alteración en el resultado de una ecografía mamaria, categorizada según el Breast Imaging Reporting and Data System (BIRADS) como categoría IV (hallazgo sospechoso) en mama izquierda, con masa irregular de 6 cm, mixta sólido/quística, calcificada, con vascularización al doppler, con adenomegalias axilares ipsilaterales (Figura 2). A la mamografía comparativa BIRADS III, mama izquierda con masa lobulada retroareolar. Ya tenía biopsia de mama del año anterior, con diagnóstico de adenosis, hiperplasia epitelial usual y microquistes.

En la consulta, la paciente niega dolor mamario o telorrea. En el examen físico presenta presión arterial 160/80 mmHg, frecuencia cardíaca de 90 latidos/min. Se nota en la mama izquierda una masa nodular dura, adherida a la piel, de 7 cm, retroareolar, con adelgazamiento cutáneo. No se encuentran adenopatías.
Se ordenó nueva biopsia de mama con aguja cortante, el resultado fue: proliferación de estructuras tubulares a clasificar por inmunohistoquímica (IHQ). La miosina de cadena pesada, la P63 y las citoqueratinas 5/6 fueron todas positivas, lo que confirma una lesión benigna. Se hace el diagnóstico de AME. Se considera un tumor de comportamiento incierto y se programa para mastectomía y biopsia por congelación de ganglio centinela, con posibilidad de linfadenectomia axilar.
Se realizó el procedimiento quirúrgico sin complicaciones. Hubo dos ganglios centinelas negativos para malignidad. El tumor de 7 cm, márgenes negativos a más de 0.2 cm. Se realizó IHQ AE1-3 (+), CK 5/6 (+), CK 3/4 (-), BETA12 (+), Receptor Progesterona (-), Receptor Estrógenos (+), S100 (+), calponina (+), p63 (+) HER2 (-), KI67 2%. Al examen físico de la región pectoral izquierda queda una cicatriz en buen estado, equimosis leve, no infección, dren con secreción serosa de 15 cc. Se ordenó retiro dren (Figura 3). Se realizó seguimiento clínico e imagenológico cada 6 meses sin signos de recaída.

Figura 3. Imagen original del caso durante el posquirúrgico inmediato.
DISCUSIÓN
Los AME son tumores redondos, lobulados, circunscritos y duros1,8. Pueden tener configuración multinodular o papilar y cambios quísticos9,24,25. En general, se presenta como una masa mamaria única, palpable, unilateral9 de 2.5 cm en promedio1,9. La evolución es de varios meses1. Habitualmente se localizan en los cuadrantes externos de la mama8, y pocas veces presentan dolor o telorrea1. El diagnóstico diferencial incluye adenosis esclerosante, fibroadenoma, adenoma tubular y adenoma pleomorfo.
En la mamografía y ecografía la lesión aparece como una masa lobulada, densa, y circunscrita, con calcificaciones y quistes, puede ser clasificada como BIRADS III o IV. No tiene un hallazgo específico en imágenes23. La observación clínica y radiológica es insuficiente por lo que se necesita la histología para confirmar el diagnóstico. La citología por aspiración con aguja fina (BACAF) es difícil26 y se recomienda la biopsia con aguja gruesa (TRUCUT), sin embargo resulta ser un reto para el patólogo por la heterogeneidad morfológica27,14. Si el material de la biopsia es escaso, puede confundirse con otras lesiones, incluso con un carcinoma invasivo28,29, por lo que el procedimiento diagnóstico final es la biopsia por escisión o mastectomía.
Puede haber malignidad en el componente mioepitelial llamado mioepitelioma maligno o leiomiosarcoma, o en ambos componente celulares (AME maligno), lo que es excepcionalmente raro (solo se han reportado 30 casos)23,24,30,31. Histológicamente se caracteriza por un componente de células fusiformes, infiltración local, tasa mitótica aumentada de más de 5 por 10 campos de alta potencia, o atipia celular19,20.
El AME maligno tiene el potencial de metástasis a distancia, en el caso de tumores de más de 2 cm24 y alto grado histológico23. Las metástasis se presentan en el 32% de los casos23,24, hacia pulmones, cerebro y tejidos blandos; parecen ser hematógenas más bien que linfáticas, por lo que se ha sugerido que la disección de los ganglios linfáticos axilares no está indicada a menos que sean palpables21,32.
El tratamiento incluye la escisión completa, cuidando que los márgenes sean negativos. No hay consenso sobre lo que constituye un margen negativo adecuado, sin embargo, se trata del mejor predictor de riesgo de recurrencia local1,21,22. Si la lesión recurre, se requeriría una escisión más amplia o mastectomía1,33,34.
La conducta de cirugía axilar está menos definida, y va desde la observación axilar hasta la biopsia de ganglio centinela radioguiada y el vaciamiento axilar23,24,32,35. Este último estaría indicado si hay afectación clínica de los ganglios linfáticos32.
No hay datos sobre el tratamiento adyuvante, y la respuesta a la quimioterapia y radioterapia es desconocida36.
En conclusión, los AME de mama son infrecuentes. Están caracterizados por una hiperplasia bifásica del epitelio glandular y mioepitelio de los conductos mamarios. La mayoría son benignos y el pronóstico es bueno. El diagnóstico preoperatorio es difícil y se requiere de la escisión completa del tumor para diagnóstico histológico y confirmación por inmunohistoquímica. Se necesita la resección con márgenes negativos ante un riesgo de recurrencia y transformación maligna. Hay que hacer seguimiento cercano.
REFERENCIAS
1. Tavassoli FA. Myoepithelial lesions of the breast. Myoepitheliosis, adenomyoepithelioma, and myoepithelial carcinoma. Am J Surg Pathol. 1991; 15(6):554-568.
2. Simpson PT, Gale T, Reis-Filho JS, Jones C, Parry S, Steele D, Cossu A, Budroni M, Palmieri G, Lakhani SR. Distribution and significance of 14-3-3 sigma, a novel myoepithelial marker, in normal, benign, and malignant breast tissue. J Pathol. 2004; 202(3):274-85.
3. Iyengar P, Ali S, Edi Brogi. Fine niddle aspiration cytology of mammary adenomyopithelioma: A study of 12 patients. Cancer (Cancer Cytopathology). 2006; 108:250-6.
4. Gatti G, Viale G, Simsek S, Zurrida S, Intra M, Caldarella P, et al. Adenomyoepithelioma of the breast, presenting as a cancer. Tumori. 2004; 90:337-9.
5. Hamperl H. The myothelia (myoepithelial cells). Normal state; regressive changes; hyperplasia; tumors. Current Topics in Pathology. 1970; 53:161-220.
6. Khan L, Shrivastava S, Singh PK, Ather M. Benign breast myoepithelioma. J Cytol. 2013; 30:62-4.
7. Bult P, Verwiel JMM, Wobbes T, Kooy-Smits MM, Biert J, Holland R. Malignant adenomyoepithelioma of the breast with metastasis in the thyroid gland 12 years after excision of the primary tumor. Case report and review of the literature. Virchows Arch. 2000; 436:158-66.
8. Rosen PP. Adenomyoepithelioma of the breast. Hum Pathol. 1987; 18(12): 1232-7.
9. McLaren BK, Smith J, Schuyler PA, Dupont WD, Page DL. Adenomyoepithelioma: Clinical, histologic, and immunohistologic evaluation of a series of related lesions. Am J Surg Pathol. 2005; 29(10):1294-9.
10. Patchefsky AS, Hollander IJ. Adenomyoepithelioma of the breast: A spectrum of biologic behavior. Am J Surg Pathol. 1992; 16(9):868-76.
11. Ahmadi N, Negahban S, Aledavood A, Daneshbod K, Daneshbod Y. Malignant adenomyoepithelioma of the breast: A review. 2015; 21(3):291-6.
12. Erel S, Tuncbilek I, Kismet K, Kilicoglu B, Ozer E, Akkus MA. Adenomyoepithelial adenosis of the breast: Clinical, radiological, and pathological findings for differential diagnosis. Breast Care. 2008; 3:427-30.
13. Mouhsine A, Belkouch A, Atmane E, Rokhssi R, Berrada Y, Belyamani L, et al. Myoepithelial carcinoma of the breast developed in an adenomyoepithelioma: A case report. Int J Med Imaging. 2014; 2(5):109-11.
14. Yoon JY, Chitale D. Adenomyoepithelioma of the breast. A brief diagnostic review. Arch Pathol Lab Med. 2013; 137(5):725-9.
15. Gill TS, Clarke D, Douglas-Jones AG, Sweetland HM, Mansel RE. Adenomyoepithelioma of the breast: A diagnostic dilemma. Eur J Surg Oncol. 2000; 26:316-8.
16. Lakhani SR, Ellis IO, Schnitt SJ, Tan PH, Van de Vijver MJ. WHO Classification of tumors of the breast. 4th edition. WHO Press; 2012.
17. Satyanarayana V, Gole S. Adenomyoepithelioma a rare breast tumor: Case studies with review of the literature. The Internet Journal of Pathology. 2012; 13:2.
18. Jian Z, Gaofeng N, Dan W, Qingqing H, Peifeng L. Lobulated adenomyoepithelioma: A case report showing immunohistochemical profiles. Int J Clin Exp Pathol. 2015; 8(11):15407-11.
19. Qureshi A, Kayani N, Gulzar R. Malignant adenomyoepithelioma of the breast: A case report with review of literature. BMJ Case Rep. 2009; Bcr01.2009.144
20. Han B, Mori I, Nakamura M, Wang X, Ozaki T, Nakamura K, Kakuda K. Myoepithelial carcinoma arising in an adenomyoepithelioma of the breast: Case report with immunohistochemical and mutational analysis. Pathol Int. 2006; 56(4):211-6
21. Loose JH, Patchefsky AS, Hollander IJ. Adenomyoepithelioma of the breast: A spectrum of biologic behavior. Am J Surg Pathol. 1992; 16(9):868-76.
22. Rosen PP. Myoepithelial neoplasms. In: Rosen’s Breast Pathology. 3rd ed. Philadelphia, PA: Lippincott Williams & Wilkins; 2009:137-60.
23. Hayes MM. Adenomyoepithelioma of the breast: A review stressing its propensity for malignant transformation. J Clin Pathol. 2011; 64(6):477-84.
24. Papaevangelou A, Pougouras I, Liapi G. Cystic adenomyoepithelioma of the breast. Breast. 2004; 13(4):356-8.
25. Laforga JB, Aranda FI, Sevilla F. Adenomyoepithelioma of the breast: Report of two cases with prominent cystic changes and intranuclear inclusions. Diagn Cytopathol. 1998; 19(1):55-8.
26. Lee WY. Fine needle aspiration cytology of adenomyoepithelioma of the breast: A case indistinguishable from phyllodes tumor in cytological findings and clinical behavior. Acta Cytol. 2000; 44:488-90.
27. Petrozza V, Pasciuti G, Pacchiarotti A, Tomao F, Zoratto F, Rossi L, et al. Breast adenomyoepithelioma: A case report with malignant proliferation of epithelial and myoepithelial elements. World J Surg Oncol. 2013; 11:285.
28. Saad RS, Richmond L, Nofech-Mozes S, Ghorab Z. Fine-needle aspiration biopsy of breast adenomyoepithelioma: A potential false positive pitfall and presence of intranuclear cytoplasmic inclusions. Diagn Cytopathol. 2012; 40:1005-9.
29. Warrier S, Hwang S, Ghaly M, Matthews A. Adenomyoepithelioma with ductal carcinoma in situ: A case report and review of the literature. Case Rep Surg. 2013; 2013:521417
30. Choi SY, Kim JS, Kim SJ, Kim YJ, Kim L, Young UC. Malignant adenomyoepithelioma of the breast presenting as a large mass that grew slowly without metastasis. Journal of Breast Cancer. 2009; 12(3):219-22.
31. Khurana A, Jalpota Y. Myoepithelial carcinoma arising in an adenomyoepithelioma of the breast: A case report of a rare entity. Indian Journal of Pathology and Microbiology. 2010; 53(2):310-2.
32. Awamleh AA, Gudi M, Shousha S. Malignant Adenomyoepithelioma of the breast with lymph node metastasis: A detailed immunohistochemical study. Case Reports in Pathology. 2012; 2012:305858-305858.
33. Wiens N, Hoffman DI, Huang CY, Nayak A, Tchou J. Clinical characteristics and outcomes of benign, atypical, and malignant breast adenomyoepithelioma: A single institution's experience. Am J Surg. 2019; pii: S0002-9610(19)30363-0.
34: Yuan Z, Qu X, Zhang ZT, Jiang WG. Lessons from managing the breast malignant adenomyoepithelioma and the discussion on treatment strategy. World J Oncol. 2017; 8(4):126-31.
35. Howlett DC, Mason CH, Biswas S. Adenomyoepithelioma of the breast: Spectrum of disease with associated imaging and pathology. AJR Am J Roentgenol. 2003; 180:799-803.
36. Woodward WA, Chen MS, Behbod F, Rosen JM. On mammary stem cells. J Cell Sci. 2005; 118(Pt 16):3585-94.
Notas de autor
mastologia.bonilla@gmail.com
Información adicional
DECLARACIÓN DE CONFLICTOS DE INTERÉS: El autor declara no tener ningún conflicto de interés.